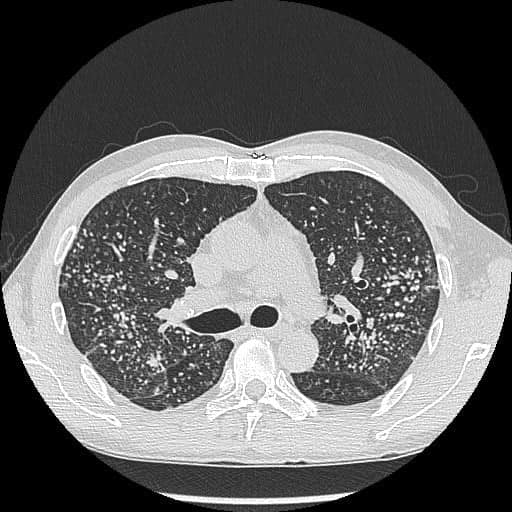

观察手指也可看出肺部问题?有医生分享病例指,一名40岁男子常常气喘,手指出现1种特征,求医检查后验出肺结节。出现此情况,是否代表患肺癌风险也较高?
常气喘手指现1特征 验出肺结节
胸腔内科医生苏一峰在其facebook专页发文指,该名40岁男子平日没有吸烟习惯,但近几个月出现不断气喘的情况,遂往医院求医。医生一看,发现该男子的手指明显是“杵状指”,而且几乎十只手指也变成“杵状指”。医生随即安排他照X光,结果验出肺结节,就如“满天星”。
▲该名40岁男子出现“杵状指”(图片来源:“胸腔内科医生苏一峰”facebook专页)
▲照X光发现,该男子长满肺结节,如“满天星”。(图片来源:“胸腔内科医生苏一峰”facebook专页)
自测杵状指症状 恐是肺癌征兆?
为何会出现“杵状指”?有何特征?苏一峰医生曾指出,“杵状指”好发于心肺疾病患者,并不一定与肺癌有关,只是以肺癌、肺阻塞等肺部疾病最为常见。
肺癌细胞所分泌的荷尔蒙激素也容易造成骨头增生,令手指可能会呈现“杵状指”。此外,身体经常缺氧容易导致四肢末端的骨头增生肿大。
苏一峰医生教如何分辨杵状指,自测方法及步骤如下:
伸出左右手指,并呈勾状
两手指靠近互相併拢
一般人在两手靠拢后,手指中间会有一个菱形空隙
如发现空隙消失,恐出现杵状指
肺癌6大成因及7大症状 厨房油烟增风险
肺癌为香港头号致命癌症,根据香港医管局资料,肺癌是一种恶性肿瘤,通常于下呼吸道系统,如支气管和细支气管的表皮细胞等部位产生。肺癌若能够提早发现,能够提高治癒率。
可惜,大部分病人确诊患上肺癌时已达中期或晚期,增加了治疗的难度。因此高危人士(吸烟人士与经常吸食二手烟的人)要对呼吸道疾病保持警觉,以便及早发现肺癌,增加治癒率。
肺癌有何常见症状?
持续性咳嗽
痰中带血
胸肺反覆受到感染或经久难癒
声音嘶哑
胸部不适,咳嗽或深呼吸时感到疼痛
食慾不振及体重下降
容易疲倦
甚麽因素易引发肺癌?
吸烟或常吸入二手烟
长期缺乏进食新鲜蔬菜、水果和含丰富维他命A的食物
长期吸入厨房油烟
经常进食经烧烤、醃制的食物
长期吸入燃烧香烛的烟雾
种族或遗传因素
资料来源:胸腔内科医生苏一峰、香港癌症网上资源中心、香港医管局